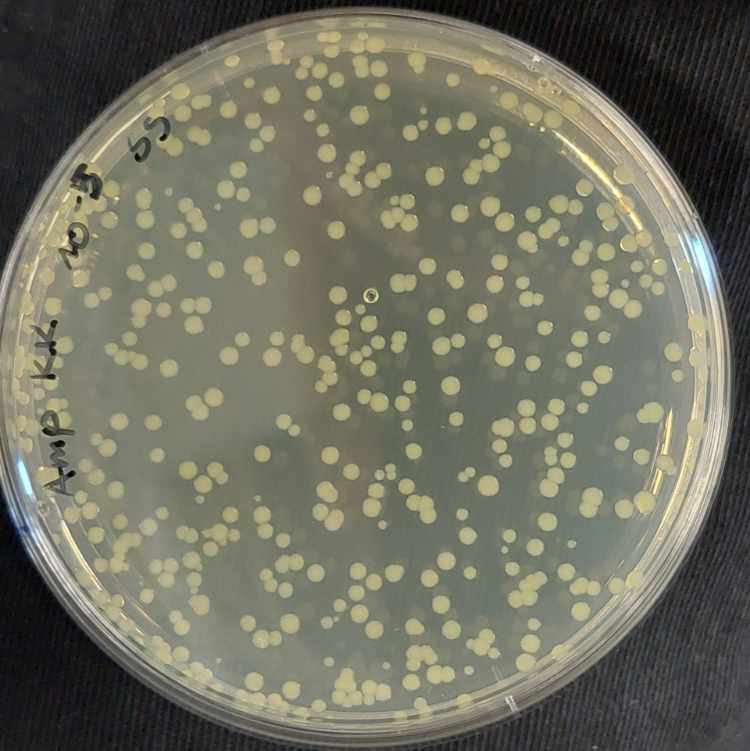
05.jpg

Spaces:
Running
on
Zero
Running
on
Zero
- SHA256:
- a52601b341c8f5ee0bcad6797dc7418bddda7b98f26d4ab14ab5822c25e41e1e
- Pointer size:
- 130 Bytes
- Size of remote file:
- 46.6 kB
- Xet hash:
- fa01304e0ece1163c6d533ff37806fbbe19558d3876e9af62e43d6bef81aef00
·
·
Xet efficiently stores Large Files inside Git, intelligently splitting files into unique chunks and accelerating uploads and downloads. More info.